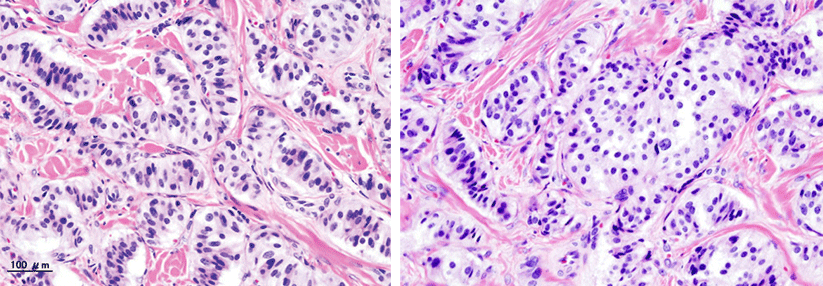

Pankreaskarzinom: Per Liquid Biopsy viele Risikogene gleichzeitig prüfen
 Mit Next Generation Sequencing konnten Veränderungen der Allelfrequenz im Verlauf der Behandlung gemessen werden.
© Fotolia/HYUNGKEUN
Mit Next Generation Sequencing konnten Veränderungen der Allelfrequenz im Verlauf der Behandlung gemessen werden.
© Fotolia/HYUNGKEUN
Das Pankreaskarzinom wird in der Regel zu spät entdeckt, sodass es meist nicht mehr kurativ behandelt werden kann. Was fehlt, sind zuverlässige, aus dem Blut zu gewinnende Biomarker, die eine möglichst frühe Diagnose und ein nicht-invasives Therapie-Monitoring ermöglichen. Als Alternative zum Proteinbiomarker CA19-9, dessen Sensitivität und Spezifität als unbefriedigend gilt, verfolgen Forscher den Ansatz der Liquid Biopsy: Hier wird zirkulierende Tumor-DNA (ctDNA) auf tumorassoziierte Mutationen in bestimmten Genen hin untersucht. Beim Pankreaskarzinom ist das Onkogen KRAS von besonderem Interesse, es ergibt sich hiermit jedoch kein geeignetes Gesamtbild.
Mit einem Durchgang 83 Gene gleichzeitig getestet
Hier könnten tiefe Sequenziermethoden Abilfe schaffen, mit denen man nach Veränderungen in definierten größeren Regionen des Krebsgenoms sucht. Um Vor- und Nachteile dieser Strategie besser abwägen zu können, untersuchten koreanische Onkologen und Molekularpathologen Proben von 17 Patienten mit pankreatischem Adenokarzinom mit tiefer Sequenzierung (Next Generation Sequencing, NGS), wobei nach 83 Genen gesucht wurde, die bei diesem Tumor verändert sein können. Von allen 17 Patienten standen Feinnadel-Biopsien sowie insgesamt 69 zu verschiedenen Zeitpunkten entnommene Blutproben zur Verfügung.
In Blutproben, die vor Beginn einer Therapie gewonnen worden waren, fanden sich nur bei zehn der 17 Patienten KRAS-Mutationen. Dagegen konnte bei Sequenzierung der 83-Gen-Palette in 15 Fällen zirkulierende Tumor-DNA nachgewiesen werden (Sensitivität 88,2 %) – also somit auch in Proben von Patienten, bei denen keine KRAS-Mutationen detektiert wurden.
Gesucht: zuverlässige Biomarker beim Pankreaskarzinom
- der Tumorlast
- der genetischen Heterogenität innerhalb eines Tumors
- des Auftauchens von Resistenzmutationen
- der klonalen Expansion in der Entwicklung eines Malignoms
Allelfrequenz korreliert mit Therapieansprechen
Anhand der Proben, die zu unterschiedlichen Zeitpunkten im Verlauf der Therapie genommen wurden, überprüften die Wissenschaftler, ob sich die tiefe Sequenzierung zum Monitoring der Erkrankung eignet: Gemessen wurde hierzu die Allelfrequenz, also wie häufig bestimmte Allele in den Proben in verschiedenen Stadien der Erkrankung auftraten. Die Konzentrationen der mutierten Gene korrelierten dabei mit dem Ansprechen. Wenn die Patienten unter der Behandlung eine komplette oder partielle Remission erzielten, fand sich also entsprechend die niedrigste Allelfrequenz. Die Autoren schlussfolgern, dass sich mit dieser Methode der Erkrankungsstatus in Echtzeit abbilden lässt. Eine tiefe Sequenzierung habe somit durchaus Vorteile: Man könne damit sehr sensitiv die Anwesenheit eines Pankreastumors nachweisen. Eine Verlaufskontrolle wäre denkbar, da die Messungen gut mit dem Ansprechen auf die Therapie bzw. mit einer Progression der Erkrankung korrelierten.Quelle: Park G et al. Sci Rep 2018; 8: 11631